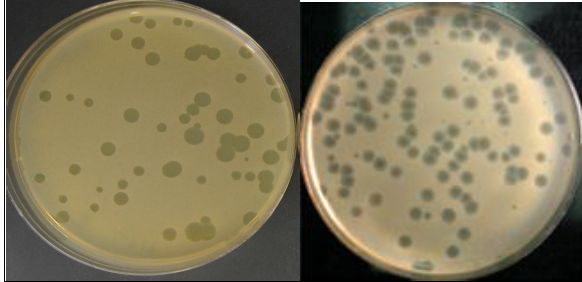

النبات

مواضيع عامة في علم النبات

الجذور - السيقان - الأوراق

النباتات الوعائية واللاوعائية

البذور (مغطاة البذور - عاريات البذور)

الطحالب

النباتات الطبية


الحيوان

مواضيع عامة في علم الحيوان

علم التشريح

التنوع الإحيائي

البايلوجيا الخلوية


الأحياء المجهرية

البكتيريا

الفطريات

الطفيليات

الفايروسات


علم الأمراض

الاورام

الامراض الوراثية

الامراض المناعية

الامراض المدارية

اضطرابات الدورة الدموية

مواضيع عامة في علم الامراض

الحشرات


التقانة الإحيائية

مواضيع عامة في التقانة الإحيائية


التقنية الحيوية المكروبية

التقنية الحيوية والميكروبات

الفعاليات الحيوية

وراثة الاحياء المجهرية

تصنيف الاحياء المجهرية

الاحياء المجهرية في الطبيعة

أيض الاجهاد

التقنية الحيوية والبيئة

التقنية الحيوية والطب

التقنية الحيوية والزراعة

التقنية الحيوية والصناعة

التقنية الحيوية والطاقة

البحار والطحالب الصغيرة

عزل البروتين

هندسة الجينات


التقنية الحياتية النانوية

مفاهيم التقنية الحيوية النانوية

التراكيب النانوية والمجاهر المستخدمة في رؤيتها

تصنيع وتخليق المواد النانوية

تطبيقات التقنية النانوية والحيوية النانوية

الرقائق والمتحسسات الحيوية

المصفوفات المجهرية وحاسوب الدنا

اللقاحات

البيئة والتلوث


علم الأجنة

اعضاء التكاثر وتشكل الاعراس

الاخصاب

التشطر

العصيبة وتشكل الجسيدات

تشكل اللواحق الجنينية

تكون المعيدة وظهور الطبقات الجنينية

مقدمة لعلم الاجنة


الأحياء الجزيئي

مواضيع عامة في الاحياء الجزيئي


علم وظائف الأعضاء


الغدد

مواضيع عامة في الغدد

الغدد الصم و هرموناتها

الجسم تحت السريري

الغدة النخامية

الغدة الكظرية

الغدة التناسلية

الغدة الدرقية والجار الدرقية

الغدة البنكرياسية

الغدة الصنوبرية

مواضيع عامة في علم وظائف الاعضاء

الخلية الحيوانية

الجهاز العصبي

أعضاء الحس

الجهاز العضلي

السوائل الجسمية

الجهاز الدوري والليمف

الجهاز التنفسي

الجهاز الهضمي

الجهاز البولي


المضادات الميكروبية

مواضيع عامة في المضادات الميكروبية

مضادات البكتيريا

مضادات الفطريات

مضادات الطفيليات

مضادات الفايروسات

علم الخلية

الوراثة

الأحياء العامة

المناعة

التحليلات المرضية

الكيمياء الحيوية

مواضيع متنوعة أخرى

الانزيمات
لوحات العاثي Phage Plaques
المؤلف:
د.زهرة محمود الخفاجي
المصدر:
موسوعة الحياة
الجزء والصفحة:
25-7-2019
1500
لوحات العاثي Phage Plaques
مناطق منع فيها نمو الخلايا المضيفة مثل البكتريا ، نظراً لكون الفيروسات صغيرة ولا تتكاثر إلا داخل الخلايا الحية لذلك لا يمكن عدها بطريقة مباشرة وإنما تعد بواسطة عد مناطق منع النمو (Plaque) التي تظهر من إضافة نماذج حاوية على العاثيات على وسط غذائي يحوي على البكتريا الحساسة للعاثي وعند إضافة العاثي لها تظهرمناطق خالية من النمو في خليفة من الخلايا النامية للبكتريا على الوسط الغذائي وبالتالي يمكن حساب عدد العاثيات في النموذج الأصلي من عد هذه المناطق وعادة تكون اللوحات الخالية من النمو البكتري متشابه بالنسبة للعاثي الواحد من حيث الحجم والحافات والشفافية وبهذا يمكن معرفة فيما إذا كان هناك أكثر من نوع من العاثيات في النموذج التي تؤثر في البكتريا الحساسة لها .
وتتم عملية عد لوحات العاثيات بأن تحضر أطباق بتري حاوية على أوساط غذائية ملائمة لتنمية الخلايا الحساسة للعاثيات ، ثم يُحضر أكار بنسبة 0.6–0.8 % (شبه صلب) ويكون بدرجة حرارة 45 -50 م يضاف إليه حجم معين من تخافيف النموذج الحاوي على العاثي ويضاف أيضاً عدداً محدداً من الخلايا الحساسة (بحيث يعطي نمولمستعمرات منفصلة ولكن متقاربة جداً Lawn في الطبق الاصلي) وتخلط جيداً وتصب فوق الأطباق المحضرة وتترك لتتصلب حيث أن كمية الأكر المضافة في الطبقة العلوية كافية للتصلب دون إعاقة العاثيات في عملها، وبعد ذلك تحضن الأطباق واثناء مدة الحضن الأولى تكون خلايا البكتريا فعالة في النمو والتكاثر ويكون العاثي أيضاً في حالة فعالة مما يؤدي إلى قتل الخلايا الفعالة وعند استمرار النمو تقل فعالية الخلايا وتنحسر فعالية العاثي التي تحدد بمناطق خالية من النمو بينما تستمر بقية المناطق بالنسبة للبكتريا بالنمو وبالتالي تظهر المناطق التي فيها العاثي خالية من النمو وسط خليفة من نمو الخلايا البكترية وتظهر لوحات عادة شفافة في الوسط ولكن بعض الأحيان يظهر فيها نمو شفاف جداً أو بعض المستعمرات الواضحة وذلك يعود إلى أن بعض الخلايا قد تطورت فيها المقاومة للعاثيات مما يجعلها تستمر في النمو حتى عند وجود العاثيات :
الاكثر قراءة في البكتيريا
اخر الاخبار
اخبار العتبة العباسية المقدسة
الآخبار الصحية

قسم الشؤون الفكرية يصدر كتاباً يوثق تاريخ السدانة في العتبة العباسية المقدسة
"المهمة".. إصدار قصصي يوثّق القصص الفائزة في مسابقة فتوى الدفاع المقدسة للقصة القصيرة
(نوافذ).. إصدار أدبي يوثق القصص الفائزة في مسابقة الإمام العسكري (عليه السلام)